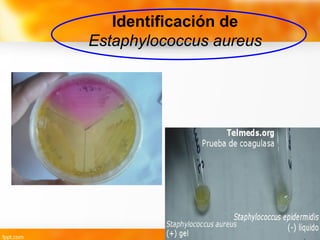
Identificación de
Estaphylococcus aureus

Este documento describe varias enfermedades transmitidas por alimentos causadas por bacterias Gram positivas, incluyendo intoxicación estafilocócica (causada por Staphylococcus aureus), botulismo (Clostridium botulinum), intoxicación por Bacillus cereus e intoxicación por Clostridium perfringens. También describe listeriosis causada por Listeria monocytogenes. Se proporcionan detalles sobre los síntomas, periodos de incubación, factores que favorecen el crecimiento de bacterias y medidas preventivas para cada enfermedad.